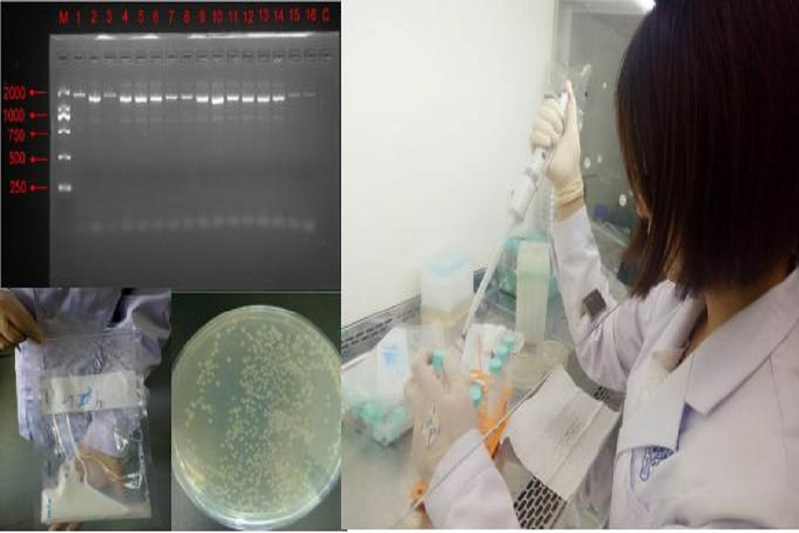

买过牛奶的朋友,可能都会产生类似的疑问:国产常温奶质量安全吗?营养全面吗?生产环境卫生吗?2019年7月到8月,为了给消费者还原一个真实的、透明的牛奶,更是为了贯彻落实党中央“健康中国2030”理念--全面提高国民体质,上海海洋大学食品学院的暑期社会实践团队以“健康中国·乳业先行”为主题,零距离接近奶源地,剖析常温奶的营养与质量安全。同时,实践团队聚焦消费者选购常温奶的行为差异,对长三角地区城乡居民常温奶的消费现状展开了调研。
深入长三角调查奶源基地
调研组组员们两两分工合作,于7月12日至8月11日,先后在浙江湖州、浙江绍兴、江苏扬州、江苏昆山及上海崇明等地区的25个城镇进行实地走访、面对面访谈以及问卷调查。针对消费者关注的奶源质量问题,组员们先后到达上海光明乳业、浙江一景乳业以及江苏华兴乳业等常温奶奶源基地,深入调查奶源基地的实际生产条件、品质要求以及卫生状况。
调查结果发现,于奶源基地抽样的54份被检液态奶样品中大肠杆菌(参照国标法GB47893-2010)、金黄色葡萄球菌(参照国标法GB478910-2010)、沙门氏菌(参照国标法GB47894-2010)等食源性致病菌数均未超标。调研组成员深入了解到自“十二五”以来长三角地区各省市陆续取消散户养牛,积极推广智能化奶牛养殖,原料奶质量安全水平不断提升。常温奶全产业链的每个环节都精益求精,力求达到“营养、健康、美味”的卓越品质。乳制品消费领先的上海市对于奶源质量安全控制更是走在全国前列,奶源监测数据目前实行“十天一报”制度,乳制品质量实行第三方检测,以确保消费者“舌尖上的安全”。

江苏调研组在扬州市参观华兴乳业奶源基地
无菌实验室进行食源性致病微生物指标检测
进企业访谈乳业老总
走访过程中,调研组也与扬州市华兴乳业有限公司刘永华总经理展开访谈。“我们每一项数据都是有记录的。不单单是纸质版记录,为了强调客观性,每一项数据都是严格电脑网络监控,做到实时报道。并且严格按照国家标准来生产牛奶,企业有着一整套的生产流水线。”刘经理这样描述。刘经理毫不避讳地提到,食品安全最重要的就是有责任心。企业必须要注重源头把控,不能因为它有挑战性就知难而退,我们要坚守本心,在道德层面上寻求高标准。针对消费者比较关心的“进口奶是不是比国产奶好”的问题,刘经理表示,对每一瓶送出的牛奶做到保质保量,将变质的可能降到最低是所有乳制品企业的期望与奋斗方向,并正在一步步实现。在食品安全性方面,不论国产常温奶还是进口常温奶,其理化成分、微生物指标等都符合我国食品安全国家标准,但在品质方面,国产奶的品质明显优于进口奶。
调研组成员在经过了详细的了解和询问之后发现,近年来,通过政府的严格监管,企业的严格把控,长三角地区乳制品的质量安全水平达到历史最好的状态。消费者想喝优质奶,还是应选择喝本土奶、身边的奶。

与江苏扬州市华兴乳业有限公司刘永华总经理请教交流
赴城镇寻访当地居民
7月12至8月11日期间,调研组成员先后在玉山镇(昆山)、卸甲镇(扬州)、书院镇(上海)、泗安镇(湖州)以及山下村(绍兴)等25个城镇进行了探访。调研发现,长三角地区有食用乳制品习惯的居民接近八成集中在城市,而农村相对较少。目前农村乳制品人均消费量远低于城市,这是当前乳制品消费的短板,同时也是乳制品供给侧改革应该关注的重点。在受访的农村居民中,74.6%居民没有饮用乳制品的习惯,小部分农村消费者认为只有儿童需要经常性喝牛奶增强体质。
而在被调研的消费者中,69.4%男性没有饮用乳制品的习惯,女性则为27.2%。79.5%的消费者没有接受过关于常温奶的科普宣传,其中只有6.9%的消费者能够准确区分不同类型的牛奶,37.6%的消费者只能简单区分。
但实践团队成员在与农村居民进一步交流中发现,随着生活水平的提高,人民对美好生活的需求日益增长,很大一部分农村居民已经意识到不仅仅要吃饱,更是要往营养、健康的方向发展,在了解牛乳的营养价值后,他们非常愿意在日常饮食中增加乳制品消费,提高“牛格尔系数”,即增加牛乳支出总额占食品总支出总额的比重。

上海调研组在崇明地区对农村居民进行关于常温奶购买情况的访谈

浙江调研组在湖州市开展城乡居民常温奶消费现状调研
本次暑期社会实践中,大家零距离地接触了“乳品安全”与“健康”,发现现阶段长三角地区奶源质量控制严格,奶企生产规范符合国家标准,但也发现常温奶消费存在城乡差异大,农村乳品消费相对较低等问题,值得我们关心和重视。相信通过政府、企业、零售商等多方协作形成合力,共同打造可持续发展的常温奶消费体系,农村居民也能够天天饮用常温奶,为美好生活加杯奶。
撰稿:张苑怡 摄影:沙港 周滢 姚元馨